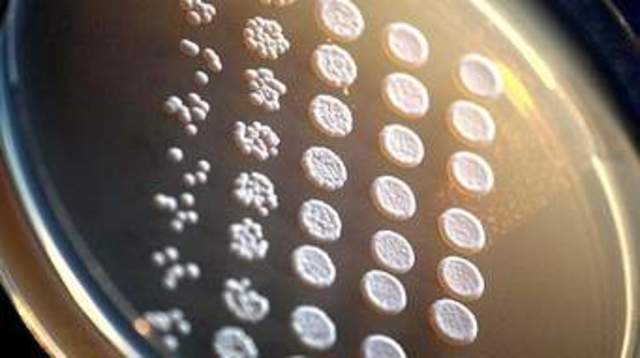
levadura fresca

-
estudio de saccaromices cervissiae
-
1880, se comienza a utilizar levadura de cerveza
-
1887, la panadería comenzó a disponer de una levadura fresca que daba mejores resultados que la levadura de cerveza. Esta nueva levadura se denominó levadura prensada
-
mayor tiempo de duracion
Looking for a timeline maker?
Create timelines for projects, roadmaps, history, lessons, legal cases, and stories with Timetoast. Timetoast is a timeline maker for work, school, research, and stories.